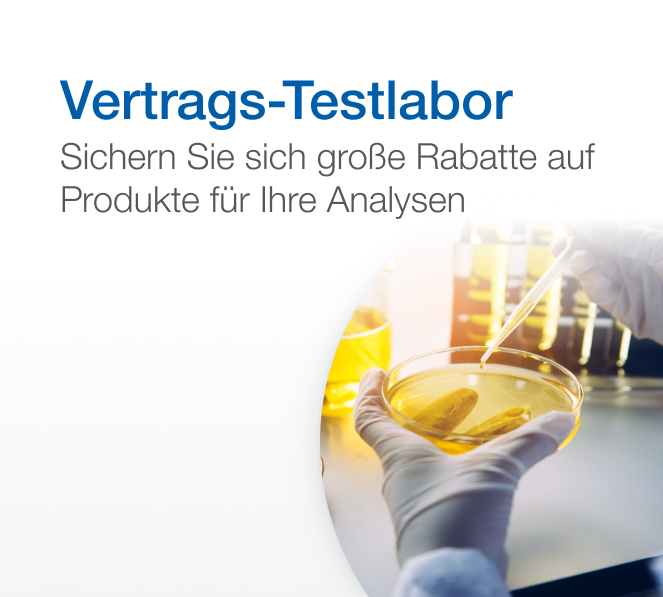

Vertrags-Testlabor

Optimieren Sie Ihr Vertrags-Testlabor mit präzisen Lösungen
Entdecken Sie unsere Premium-Auswahl für Vertrags-Testlabore! Wir bieten hochmoderne Biologika, hochreine chemische Reagenzien und erstklassige Geräte, die entwickelt wurden, um die Genauigkeit, Zuverlässigkeit und Reproduzierbarkeit Ihrer Ergebnisse zu gewährleisten. Verbessern Sie Ihre Analysen mit unseren erstklassigen Lösungen und halten Sie die höchsten Standards wissenschaftlicher Integrität und Glaubwürdigkeit ein.
Geben Sie den Aktionscode 24138 an der Kasse ein, um exklusive Rabatte auf Ihren Einkauf zu erhalten. Nutzen Sie unsere außergewöhnliche Auswahl und unschlagbaren Preise noch vor dem 30. April 2025*.
Finden Sie Ihre Produkte in den unten aufgeführten Kategorien oder stöbern Sie in der vollständigen Produktliste darunter.
Keine passende Kategorie
Wir konnten die Kategorie, nach der Sie suchen, nicht finden.
- Filtration
- Glaswaren
- Andere Plastikartikel
- Pipettenspitzen
- Pipetten und Dispenser
- Kunststoffflaschen
Handhabung von Glas, Kunststoff und Flüssigkeiten
- Verbrauchsmaterialien für die Chromatographie
Chromatographie
- Laborzubehör
Laborverbrauchsmaterialien
- Blender und Homogenisator
- Konstante Temperatur
- Heizplatten und Rührer
- Vortexmischer
- Waschmaschinen und Trockner für Glaswaren und Zubehör
Laborgeräte
- Life Science-Instrumente
- Mikrobiologie
Life Science und klinische Forschung
Gefilterte Suchergebnisse
Fisherbrand™ Becher in niedriger Form
Hergestellt aus Borosilikatglas. Fisherbrand™ Bechergläser mit breiter Form sind mit einer Messskala versehen und mit einer Vielzahl an Fassungsvermögen erhältlich

Versand am Tag der Bestellung für Produkte, die vor 14 Uhr bestellt wurden. Versand am nächsten Arbeitstag bei Bestellung nach 14 Uhr.
Erfahren Sie mehr
| Zertifizierung/Konformität | ISO 3819, DIN 12331 |
|---|---|
| Farbe | Durchscheinend |
| Modell | Niedrig |
| Einwegprodukt | Reusable |
| Enthält | Ausguss |
| Graduated | Ja |
| Scale | Weiße Skala mit Graduierung |
| Typ | Becher |
| Material | Borosilikatglas (Typ 1) |
| Autoklavierbar | Autoclavable |
| Ausführung | Matt |
Fisherbrand™ Messkolben aus Borosilikatglas mit Stopfen, transparent, Klasse A
Hergestellt aus Borosilikatglas und entsprechend ISO 1042 und DIN 12664. Die Fisherbrand™ Messkolben aus durchsichtigem Borosilikatglas, Klasse A, mit Stopfen sind mit einer Messmarkierung versehen und mit einem austauschbaren Stopfen aus Polyethylen ausgestattet. Das Fisherbrand™ Batch Certificate of Compliance steht auf der Registerkarte Documentation zum Herunterladen zur Verfügung.

Versand am Tag der Bestellung für Produkte, die vor 14 Uhr bestellt wurden. Versand am nächsten Arbeitstag bei Bestellung nach 14 Uhr.
Erfahren Sie mehr
| Zertifizierung/Konformität | ISO 1042, DIN 12664 |
|---|---|
| Farbe | Klar |
| Verschlussmaterial | Polyethylen |
| Graduated | Ja |
| Material | Borosilikatglas |
| Klasse | A |
Thermo Scientific™ Finntip™ Pipettenspezifische Spitzen „Greener Choice“-Produkt
„Greener Choice“-Produkt
Diese Produkt bietet einen oder mehrere umweltfreundliche Vorteile entsprechend den „Green Guides“ der FTC der USA.
Erfahren Sie mehr über das „Greener Choice“-Programm

Diese Produkt bietet einen oder mehrere umweltfreundliche Vorteile entsprechend den „Green Guides“ der FTC der USA.
Erfahren Sie mehr über das „Greener Choice“-Programm
Sorgen Sie für genaues und präzises Pipettieren. Diese Spitzen wurden mit unserer ganzen Erfahrung bei der Handhabung von Flüssigkeiten entwickelt und haben glatte, hydrophobe Oberflächen, die Flüssigkeitsretention verhindern.

Versand am Tag der Bestellung für Produkte, die vor 14 Uhr bestellt wurden. Versand am nächsten Arbeitstag bei Bestellung nach 14 Uhr.
Erfahren Sie mehr
| Gefiltert | Ungefiltert |
|---|---|
| Produktlinie | FinnTip |
Fisherbrand™ Analysenwaagen
Ausgestattet mit einem RS232-Anschluss für eine einfache Kommunikation, einem hintergrundbeleuchteten Display und einer einfachen Schnittstelle für eine unkomplizierte Bedienung sind diese Waagen perfekt für Ihren Arbeitsplatz geeignet.

Versand am Tag der Bestellung für Produkte, die vor 14 Uhr bestellt wurden. Versand am nächsten Arbeitstag bei Bestellung nach 14 Uhr.
Erfahren Sie mehr
| Stromstärke | 0,5 A |
|---|---|
| Gewährleistung | 2 Jahre |
| Abmessungen (T x B x H) | 317 x 201 x 303 mm |
| Elektrische Anforderungen | 100/240 V ∼200 mA 50/60 Hz 12/18 VA |
| Wiederholgenauigkeit | 0,0001 g |
| Displaytyp | LCD mit Hintergrundbeleuchtung |
| Wägemodi | Wägen, Teilezählen, Prozentwägen |
| Typ | Analytische Waage |
| Lesbarkeit | 0,0001 g |
| Stabilisierungszeit | 4 s |
| Zertifizierung/Konformität | GLP mit optionaler Druckerkonformität |
| Außendurchmesser (metrisch) Schale | 90 mm |
| Min. Probengewicht | 200 mg |
| Linearität | 0,0002 g |
| Frequenz | 50/60 Hz |
| Anschlusstyp | RS232 |
| Enthält | AC-Adapter |
Corning™ Pipettenspitzen zur Gelbeladung
Corning–Pipettenspitzen zur Gelbeladung–Mit Kapillarende für einfachen Zugang zu vertikalen und horizontalen Elektrophorese-Gelen.

Versand am Tag der Bestellung für Produkte, die vor 14 Uhr bestellt wurden. Versand am nächsten Arbeitstag bei Bestellung nach 14 Uhr.
Erfahren Sie mehr
Fisherbrand™ Pasteurpipetten aus Kalk-Soda Glas
Pasteurpipetten sind für den einmaligen Gebrauch in mikrobiologischen und serologischen Laboratorien bestimmt.

Versand am Tag der Bestellung für Produkte, die vor 14 Uhr bestellt wurden. Versand am nächsten Arbeitstag bei Bestellung nach 14 Uhr.
Erfahren Sie mehr
| Einwegprodukt | Einmalgebrauch |
|---|---|
| Volumen (angloamerikanisch) | 0,07 oz. |
| Menge | 1000 Packungen |
| Zur Verwendung mit (Anwendung) | Zum Einmalgebrauch für Anwendungen in mikrobiologischen und serologischen Labors, zum Pipettieren von Flüssigkeiten, tropfenweisen Dosieren von Flüssigkeiten und Reagenzien, Verteilen von Mengen erwärmter Flüssigkeiten |
| Volumen (metrisch) | 2 ml |
| Material | Kalknatronglas |
| Autoklavierbar | Nicht autoklavierbar |
| Zur Verwendung mit (Geräte) | Fisherbrand Pipetten |
Fisherbrand™ SureOne™ Pipettenspitzen mit Aerosolbarriere „Greener Choice“-Produkt
„Greener Choice“-Produkt
Diese Produkt bietet einen oder mehrere umweltfreundliche Vorteile entsprechend den „Green Guides“ der FTC der USA.
Erfahren Sie mehr über das „Greener Choice“-Programm

Diese Produkt bietet einen oder mehrere umweltfreundliche Vorteile entsprechend den „Green Guides“ der FTC der USA.
Erfahren Sie mehr über das „Greener Choice“-Programm
Auswahl aus einem umfangreichen Sortiment an Pipettenspitzen für anspruchsvolle Liquid-Handling-Anwendungen

Versand am Tag der Bestellung für Produkte, die vor 14 Uhr bestellt wurden. Versand am nächsten Arbeitstag bei Bestellung nach 14 Uhr.
Erfahren Sie mehr
| Format | Aufklappbares Gestell |
|---|---|
| Sterilität | Steril |
| Autoklavierbar | Nicht autoklavierbar |
| Gefiltert | Gefiltert |
| Zur Verwendung mit (Geräte) | Universal Fit |
| Produktlinie | SureOne |
Wasser, für die HPLC-MS, Fisher Chemical

Versand am Tag der Bestellung für Produkte, die vor 14 Uhr bestellt wurden. Versand am nächsten Arbeitstag bei Bestellung nach 14 Uhr.
Erfahren Sie mehr
Eppendorf™ Eppendorf Quality™ epT.I.P.S.™ Nachfüllpack „Greener Choice“-Produkt
„Greener Choice“-Produkt
Diese Produkt bietet einen oder mehrere umweltfreundliche Vorteile entsprechend den „Green Guides“ der FTC der USA.
Erfahren Sie mehr über das „Greener Choice“-Programm

Diese Produkt bietet einen oder mehrere umweltfreundliche Vorteile entsprechend den „Green Guides“ der FTC der USA.
Erfahren Sie mehr über das „Greener Choice“-Programm
Eppendorf™ Eppendorf Quality™ epT.I.P.S.™ Nachfüllpacks sind die perfekte Kombination, die eine kraftreduzierte Spitzenbefestigung und den kraftreduzierten Spitzenabwurf mit vollständiger Abdichtung ermöglicht.

Versand am Tag der Bestellung für Produkte, die vor 14 Uhr bestellt wurden. Versand am nächsten Arbeitstag bei Bestellung nach 14 Uhr.
Erfahren Sie mehr
| Farbe | Natural |
|---|---|
| Verpackung | Reloads |
| Autoklavierbar | Autoklavierbar |
| Gefiltert | Ungefiltert |
| Produktlinie | epT.I.P.S. |
| Reinigungsnachweise | Eppendorf Quality™ |
Eppendorf™ epTIPS™ Standard-Pipettenspitzen „Greener Choice“-Produkt
„Greener Choice“-Produkt
Diese Produkt bietet einen oder mehrere umweltfreundliche Vorteile entsprechend den „Green Guides“ der FTC der USA.
Erfahren Sie mehr über das „Greener Choice“-Programm

Diese Produkt bietet einen oder mehrere umweltfreundliche Vorteile entsprechend den „Green Guides“ der FTC der USA.
Erfahren Sie mehr über das „Greener Choice“-Programm
Diese universal einsetzbaren Pipettenspitzen eignen sich für zahlreiche Pipetten Die Eppendorf™ epT.I.P.S.™ Die Standard-Pipettenspitzen zeichnen sich durch optimales Benetzungsverhalten, hohe Transparenz und spezielle, zertifizierte Reinheitsgrade aus.

Versand am Tag der Bestellung für Produkte, die vor 14 Uhr bestellt wurden. Versand am nächsten Arbeitstag bei Bestellung nach 14 Uhr.
Erfahren Sie mehr
| Format | Bulk |
|---|---|
| Graduierungen | Fein |
| Produkttyp | Pipettenspitzen |
| Autoklavierbar | Autoklavierbar |
| Skala | Ja |
| Produktlinie | epT.I.P.S. |
| Spitzenform | Universal |
Eppendorf™ Combitips Advanced™ Pipettenspitzen – Standard, Eppendorf-Qualität „Greener Choice“-Produkt
„Greener Choice“-Produkt
Diese Produkt bietet einen oder mehrere umweltfreundliche Vorteile entsprechend den „Green Guides“ der FTC der USA.
Erfahren Sie mehr über das „Greener Choice“-Programm

Diese Produkt bietet einen oder mehrere umweltfreundliche Vorteile entsprechend den „Green Guides“ der FTC der USA.
Erfahren Sie mehr über das „Greener Choice“-Programm
Diese Spitzen lassen sich problemlos handhaben und verhindern Beschädigungen an den Handschuhen. Eppendorf Combitips Advanced™ Standard Pipettenspitzen sind auf die gestiegenen Anforderungen eines modernen Labors optimiert und werden in drei verschiedenen Reinheitsgraden angeboten. Somit findet sich für jede Anwendung die passende Spitze.

Versand am Tag der Bestellung für Produkte, die vor 14 Uhr bestellt wurden. Versand am nächsten Arbeitstag bei Bestellung nach 14 Uhr.
Erfahren Sie mehr
| Farbe | Farblos |
|---|---|
| Format | lose, in Beutel |
| Sterilität | Unsteril |
| Einwegprodukt | Single-use |
| Verpackung | 100 Pk. (4 Beutel x 25 Pck.) |
| Material | Polypropylen |
| Produkttyp | Pipettenspitzen |
| Autoklavierbar | Nicht autoklavierbar |
| Fit for Purpose | Zertifizierte Qualität |
| Skala | Ja |
| Produktlinie | Combitips Advanced |
| Spitzenform | Extra lang,Positive Verdrängung |
| Reinigungsnachweise | Eppendorf Quality (Nicht steril) |
Fisherbrand™ Graduierter Messzylinder aus Borosilikatglas, Klasse A
Messzylinder Klasse A aus Glas zur präzisen Messung von Flüssigkeiten. Fisherbrand™ Messzylinder Klasse A aus Borosilikatglas bieten eine Skala in blauer Keramikfarbe und einen Sechskantfuß.

Versand am Tag der Bestellung für Produkte, die vor 14 Uhr bestellt wurden. Versand am nächsten Arbeitstag bei Bestellung nach 14 Uhr.
Erfahren Sie mehr
| Skalenfarbe | Blau |
|---|---|
| Umfang | Blaue Keramik |
| Enthält | Konformitätszertifikat |
| Basistyp | Hexagonal |
| Material | Borosilikatglas |
| Typ | Messzylinder |
| Class | Klasse A |
| Autoklavierbar | Autoklavierbar |
Fisherbrand™ Mikroröhrchengestell aus Polypropylen „Greener Choice“-Produkt
„Greener Choice“-Produkt
Diese Produkt bietet einen oder mehrere umweltfreundliche Vorteile entsprechend den „Green Guides“ der FTC der USA.
Erfahren Sie mehr über das „Greener Choice“-Programm

Diese Produkt bietet einen oder mehrere umweltfreundliche Vorteile entsprechend den „Green Guides“ der FTC der USA.
Erfahren Sie mehr über das „Greener Choice“-Programm
Die farbcodierten Gestelle eignen sich zur Aufbewahrung von 1.5 bis 2.0 ml-Mikroröhrchen. Fisherbrand™ Mikroröhrchengestelle aus Polypropylen eignen sich zum Aufbewahren von bis zu 80 Fläschchen mit Schraubverschluss für den Einsatz auf der Arbeitsfläche oder zur Lagerung oder zum Transport von Proben. Die eingeprägten Koordinaten in den farbcodierten Gestellen erleichtern die Handhabung. Autoklavierbar und zum Einfrieren geeignet.

Versand am Tag der Bestellung für Produkte, die vor 14 Uhr bestellt wurden. Versand am nächsten Arbeitstag bei Bestellung nach 14 Uhr.
Erfahren Sie mehr
| Verschluss inklusive | Nr. |
|---|---|
| Länge (angloamerikanisch) | 8.9 in. |
| Form | Rechteckig |
| Stapelbar | Ja |
| Material | Polypropylen |
| Anzahl pro Packung | 5/Packung |
| Aufnahmevermögen | Mikroröhrchen (1,5 bis 2 ml) |
| Autoklavierbar | Autoklavierbar |
| Höhe (angloamerikanisch) | 1.1 in. |
| Zur Verwendung mit (Geräte) | Mikrozentrifugenröhrchen |
| Einschübe | Keine |
| Array | 5 x 16 |
| Positionen | 80 |
| Durchmesser (metrisch) Well | 11 mm |
| Breite (angloamerikanisch) | 2.6 in. |
| Sterilität | Unsteril |
| Breite (metrisch) | 67 mm |
| Höhe (metrisch) | 28 mm |
| Menge | 5 Packung |
| Zur Verwendung mit (Anwendung) | Ideal zur Tiefkühllagerung |
| Produkttyp | Gestell für Mikroröhrchen |
| Länge (metrisch) | 225 mm |
Fisherbrand™ SureOne™ Pipettenspitzen mit geringer Retention, mit Filter „Greener Choice“-Produkt
„Greener Choice“-Produkt
Diese Produkt bietet einen oder mehrere umweltfreundliche Vorteile entsprechend den „Green Guides“ der FTC der USA.
Erfahren Sie mehr über das „Greener Choice“-Programm

Diese Produkt bietet einen oder mehrere umweltfreundliche Vorteile entsprechend den „Green Guides“ der FTC der USA.
Erfahren Sie mehr über das „Greener Choice“-Programm
Fisherbrand™ SureOne™ Pipettenspitzen mit geringer Retention minimieren erfolgreich die Bildung von Flüssigkeitsfilmen, die sich beim Dispensieren an den Spitzenwänden ansammeln. Dies ermöglicht maximale Probenrückgewinnung und Reproduzierbarkeit.

Versand am Tag der Bestellung für Produkte, die vor 14 Uhr bestellt wurden. Versand am nächsten Arbeitstag bei Bestellung nach 14 Uhr.
Erfahren Sie mehr
| Lagerungsbedingungen | Umgebungstemperatur |
|---|---|
| Einwegprodukt | Einmalgebrauch |
| Verpackung | Filtered Rack Sterile |
| Material | Polypropylen |
| Autoklavierbar | Nicht autoklavierbar |
| Eigenschaften | Low Retention Technology, Ultra Clear Resin |
| Produktlinie | SureOne |
| Zertifizierung/Konformität | Certificate of Sterility, COA |
| Farbe | Naturfarben |
| Format | Klapp-Gestell |
| Sterilität | Steril |
| Sterilisationsmethode | Electron Beam |
| Menge | 960 |
| Zur Verwendung mit (Anwendung) | PCR and Real Time PCR, viscous samples |
| Gestellfarbe | Blau |
| Produkttyp | Pipettenspitze |
| Gefiltert | Gefiltert |
| Reinigungsnachweise | Certified Free of: Rnase/Dnase, DNA, Pyrogen, Endotoxin, Bioburden, PCR Inhibitor and ATP, Lot Traceable |
pH-Puffer, Doppelhals
F\xfchren Sie pr\xe4zise pH-Kalibrierungen mit farbcodierten Fisherbrand™ pH-Pufferflaschen mit Doppelhals durch.

Versand am Tag der Bestellung für Produkte, die vor 14 Uhr bestellt wurden. Versand am nächsten Arbeitstag bei Bestellung nach 14 Uhr.
Erfahren Sie mehr
| Zur Verwendung mit (Anwendung) | pH-Kalibrierungen |
|---|
Allgemeine Geschäftsbedingungen
*Diese Aktion gilt nur für Kunden in Österreich, Belgien, Dänemark, Finnland, Frankreich, Deutschland, Irland, Italien, Norwegen, Portugal, Spanien, Schweden, der Schweiz, den Niederlanden und dem Vereinigten Königreich. Das Angebot gilt nur für qualifizierte Bestellungen, die zwischen dem 3. Februar und dem 30. April 2025 um 23:59 Uhr MEZ bei Thermo Fisher Scientific eingehen oder solange der Vorrat reicht, je nachdem, was zuerst eintritt. Eine Liste der qualifizierten Produkte finden Sie auf dieser Seite. Das Angebot gilt nur für qualifizierte Produkte. Diese Aktion kann nicht mit anderen Rabatten oder Werbeaktionen kombiniert werden. Angebot ungültig, wo es durch bundesstaatliche, staatliche, provinzielle oder lokale Gesetze oder Vorschriften oder durch Richtlinien von Behörden oder Institutionen verboten, lizenziert oder eingeschränkt ist. Weitere Einschränkungen können gelten. MBD (Oxoid)-Artikel sind in Irland und außerhalb europäischer Länder nicht verfügbar.














